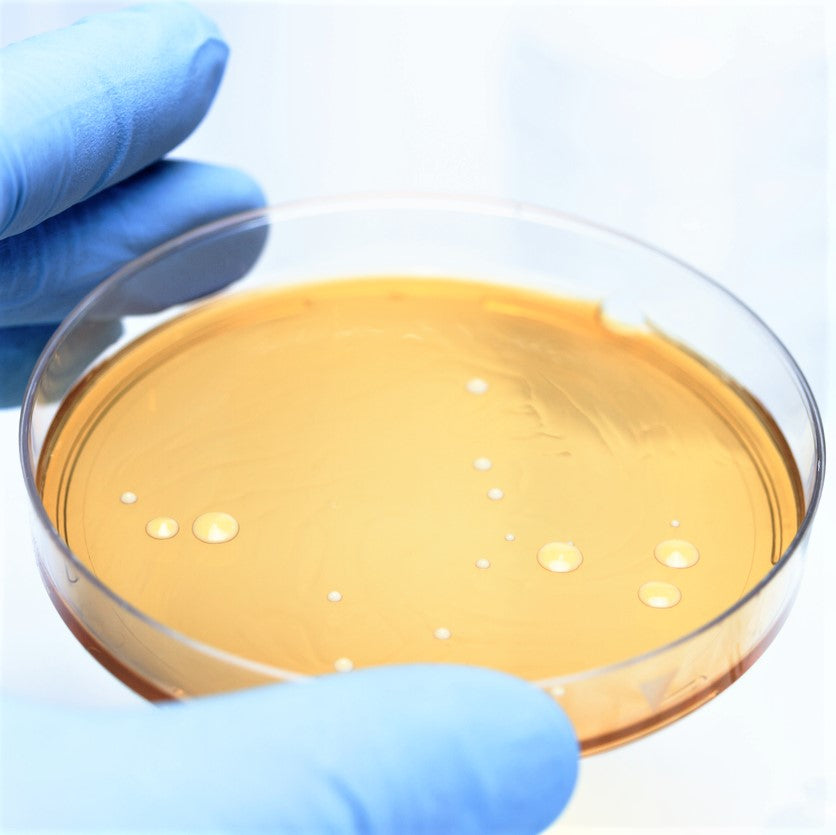

What Is Not an Element of the Skin’s Acid Mantle? The Surprising Answer! Acid mantle care for healthy skin
If you are looking for How To Protect The Acid Mantle of Your Skin Barrier – Dry Skin Love you've visit to the right web. We have 25 Pictures about How To Protect The Acid Mantle of Your Skin Barrier – Dry Skin Love like What Is Acid Mantle and Its Impact on Your Skin, Healthy Acid Mantle - A Little Less Toxic and also What is the Skin's Acid Mantle?#N#– Dry Skin Love Skincare. Here it is:
How To Protect The Acid Mantle Of Your Skin Barrier – Dry Skin Love

Acid Mantle

mantle yasalud
The Vital Importance Of The Skin's Acid Mantle | CIRCCELL SKINCARE

Acid Mantle: What We Need To Know - Indian Journal Of Dermatology

Acid Mantle Care For Healthy Skin | 100% PURE

Healthy Acid Mantle - A Little Less Toxic

THE MICROBIOME OR ACID MANTLE – Mi:skn Clinic
Is Your Acid Mantle Out Of Balance? - The Skin Cellar

acid mantle balance out can
What’s An Acid Mantle? Decoding Skincare’s New Buzzword

mantle
What Is The Skin's Acid Mantle?#N#– Dry Skin Love Skincare

What’s An Acid Mantle? Decoding Skincare’s New Buzzword

mantle skincare buzzword decoding thekit
What Your Acid Mantle Is & Why It Matters – Beauty Affairs

What Is The Skin's Acid Mantle? – Dry Skin Love Skincare

What Is Acid Mantle Of The Skin And How To Repair It?

What Is The Skin's Acid Mantle? – Dry Skin Love Skincare

What Is Acid Mantle And Its Impact On Your Skin

The Acid Mantle - Skin & Laser Clinic

mantle
Skin’s Outermost Defense Mechanisms: The Microbiome, Acid Mantle, And
mantle acid skin layer defense outermost lipid mechanisms microbiome growth bacteria
The Importance Of Acid Mantle For Great Skin Explained

What Is Acid Mantle Of The Skin And How To Repair It?

What Is Your Acid Mantle? - The Pai Life

mantle acide manteau quel
The Vital Importance Of The Skin's Acid Mantle | CIRCCELL SKINCARE

mantle acid skin importance vital what
What Is The Skin's Acid Mantle? – Dry Skin Love Skincare

Acid Mantle: What It Is And How To Repair It – Beautiful, 52% OFF

Skin’s Outermost Defense Mechanisms: The Microbiome, Acid Mantle, And

microbiome skin acid mantle layer lipid defense mechanisms outermost
Mantle skincare buzzword decoding thekit. What is the skin's acid mantle? – dry skin love skincare. Acid mantle care for healthy skin